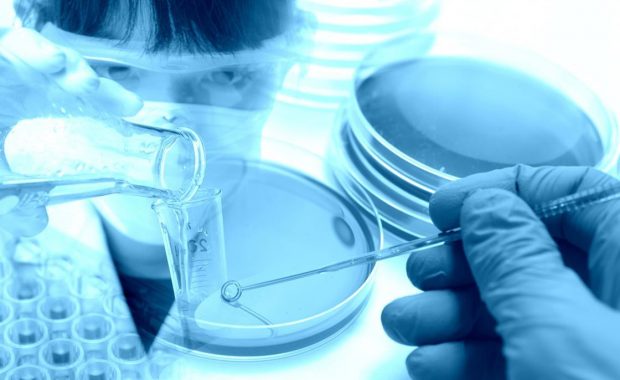

Initiated in 2017, “HyGreen Provence” aims to develop and validate the technoeconomic conditions for the production of 1,300 GWh of solar electricity,
L.A. Turbine commissions Turboexpander-Compressor
Located within the natural gas liquid (NGL) processing plant in the Bakken Shale Play of North Dakota, the ARES AMB Turboexpander-Compressor machine
Air Liquide looks to sell subsidiary
Headquartered in Germany, schülke is an expert in the hygiene and prevention of infection sector. With 130 years of experience, schülke has more than
Exclusive: KickStarter CCUS initiative launches
Beginning its journey into decarbonisation in the US, UK, Norway, the Netherlands and China, the initiative aims to enable a commercially viable CCUS
Vaisala introduce six new products
The new probes will improve customers’ process efficiencies by providing accurate and reliable measurement data for industrial processes. “With these
Purification Solutions to acquire Air/Tak
The acquisition will allow nano-purification solutions to enter into new markets whilst continuing to serve its growing customer base. The acquisition
Cook Compression opens new facility
The new facility will support the rapid reconditioning of compressor valves for ISAB S.r.l, part of the Lukoil Oil Company, and other refineries in
Linde reports Q3 results
Linde plc reported second-quarter income from continuing operations of $728m. Excluding Linde AG purchase accounting impacts and other charges,
North American Helium
Magazine Promo - North American Helium gasworld continues to keep its readers at the forefront of breaking news, insightful analysis and must-see